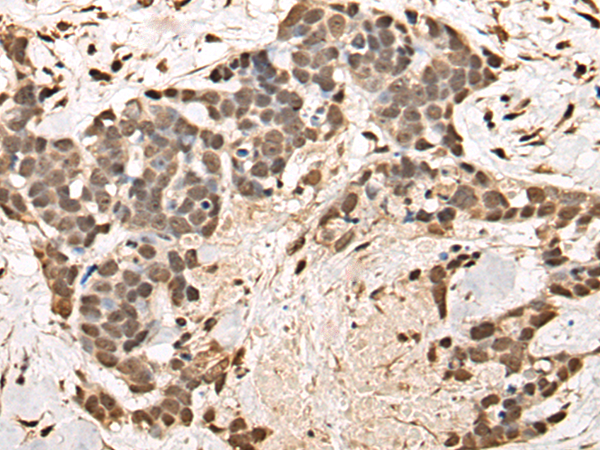

中文名稱: 兔抗BRF1多克隆抗體
|
Background: |
This gene encodes one of the three subunits of the RNA polymerase III transcription factor complex. This complex plays a central role in transcription initiation by RNA polymerase III on genes encoding tRNA, 5S rRNA, and other small structural RNAs. The gene product belongs to the TF2B family. Several alternatively spliced variants encoding different isoforms, that function at different promoters transcribed by RNA polymerase III, have been identified. |
|
Applications: |
ELISA, IHC |
|
Name of antibody: |
BRF1 |
|
Immunogen: |
Full length fusion protein |
|
Full name: |
BRF1, RNA polymerase III transcription initiation factor 90 kDa subunit |
|
Synonyms: |
BRF; CFDS; hBRF; BRF-1; GTF3B; TAF3C; TAF3B2; TF3B90; TAFIII90; TFIIIB90; HEL-S-76p |
|
SwissProt: |
Q92994 |
|
ELISA Recommended dilution: |
5000-10000 |
|
IHC positive control: |
Human ovarian cancer and human thyroid cancer |
|
IHC Recommend dilution: |
25-100 |

購物車
幫助
021-54845833/15800441009
